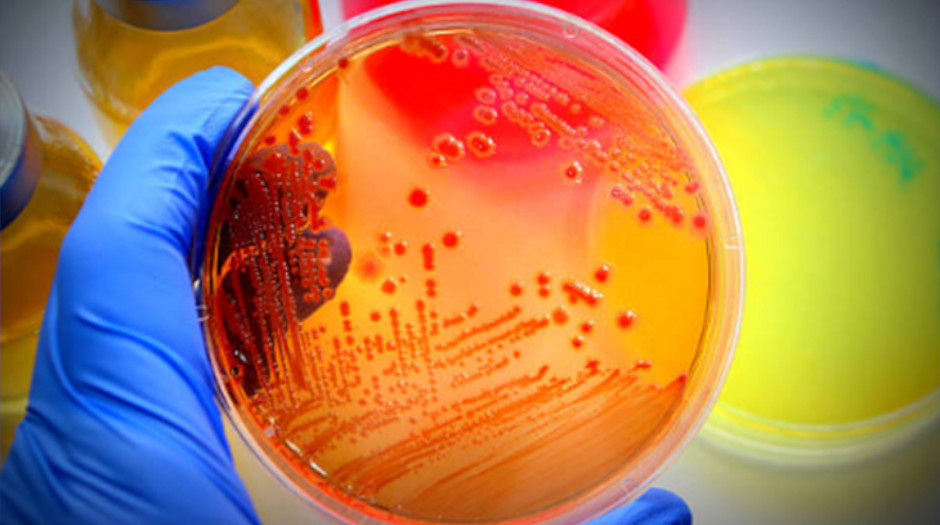
Control Microbiológico de alimentos

Control Microbiológico de alimentos
Un adecuado control microbiológico tiene un papel clave en la prevención de Enfermedades de transmisión alimentaria (ETAs). Su objetivo se basa principalmente en identificar los riesgos que pongan en peligro la inocuidad durante la fabricación de los productos alimenticios.
Un seguimiento idóneo se basará en la prevención, disminución y eliminación de estos microorganismos que tienen posibilidad de generar daños en la salud ya sea porque generan toxinas como el Clostridium botulinum o Staphylococcus aureus o porque son patogénicos como la Salmonella spp.
En WSS Perú contamos con servicios de análisis microbiológicos. Somos un laboratorio de ensayo acreditado ante INACAL y brindamos análisis de Aerobios mesófilos, Salmonella spp, Coliformes, Escherichia coli y más. Ofrecemos también una atención personalizada y orientación en los análisis a realizar de acuerdo a la industria en la que se encuentren.

